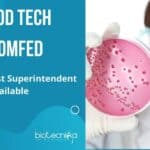
Govt Microbiology Job

Home Search
biology - search results
If you're not happy with the results, please do another search
Wildlife Institute of India Life Sciences, Botany, Zoology Jobs 2022
WII Jobs Latest 2022 For Biological Sciences, Life Sciences
WII Jobs Latest 2022 For Biological Sciences, Life Sciences. Life science job opening 2022. Zoology job...
NIANP SRF Job Openings For Biotech, Biochem, Mol Bio & Genetics
NIANP SRF Job Openings For Biotech, Biochem, Mol Bio & Genetics
NIANP SRF Job Openings For Biotech, Biochem, Mol Bio & Genetics. Bengaluru jobs. NIANP...
ICMR-NIIH Online JRF Job Application For MSc & MTech Life Sciences
ICMR-NIIH JRF Job Application For MSc & MTech Life Sciences
ICMR-NIIH JRF Job Application For MSc & MTech Life Sciences. MSc, MTech Biotech, Biochem, Life...
Govt ZSI Jr. Project Fellow Job For MSc Biosciences, Zoology & Life Sciences
ZSI Project Fellow Opening For MSc Zoology, Life Sciences
ZSI Project Fellow Opening For MSc Zoology, Life Sciences. MSc Zoology, Life Sciences, biosciences junior project...
ThermoFisher Scientific Inc. Research Associate Job For MSc Candidates With 0-3 Exp
ThermoFisher Scientific Inc. Research Associate Job For MSc Candidates
ThermoFisher Scientific Inc. Research Associate Job For MSc Candidates. MSc Molecular Biology, Immunology, Biotechnology or Biochemistry...
ACTREC JRF 2023 Online Exam For Ph.D. in Life Sciences – Apply Now
ACTREC JRF 2023 Online Exam For Ph.D. in Life Sciences - Apply Now
ACTREC JRF 2023 Online Exam For Ph.D. in Life Sciences - Apply...
IISER Bhopal PhD Programme Admissions January 2023 Notification
IISER Bhopal Admissions 2023 For PhD Programme - Applications Invited
IISER Bhopal Admissions 2023 For PhD Programme - Applications Invited. Interested candidates can check out...
Biotecnika Times Newsletter 23.09.2022 Govt OMFED Food Tech Jobs, CFTRI Admissions
Biotecnika Times Newsletter Govt OMFED Food Tech Jobs, CFTRI Admissions
Govt Food Tech Jobs at OMFED – Microbiologist Superintendent Vacancies Available
Govt Microbiology Job at OMFED,...
SGPGIMS Research Assistant Recruitment For MSc Life Sciences, Immunology, Mol Bio, Biotech & Biochem
SGPGIMS Research Assistant Recruitment For MSc Candidates
SGPGIMS Research Assistant Recruitment For MSc Candidates. SGPGIMS is recruiting candidates for research positions. Interested and eligible candidates,...
CSIR-CFTRI Admission – PhD Under University of Mysore (January 2023)
CSIR-CFTRI Admission Jan 2023 – PhD Under University of Mysore
CSIR-CFTRI Ph.D. ADMISSION (January 2023)
Ph.D. under University of Mysore
CSIR-CFTRI is a recognized organization for doing...
IACS PhD Immunology Research Associate Job Opening, Applications Invited
IACS PhD Immunology Research Associate Job Opening, Applications Invited
IACS PhD Immunology Research Associate Job Opening, Applications Invited. PhD Immunology candidates are encouraged to apply...
SRM University AP DBT Funded JRF Recruitment – Applications Invited
SRM University AP JRF Recruitment - Applications Invited
SRM University-AP, Andhra Pradesh is a multi-stream research university with a focus on diverse fields. From Engineering...
Govt Food Tech Jobs at OMFED – Microbiologist Superintendent Vacancies Available
Govt Microbiology Job at OMFED, Applications Invited
Govt Microbiology Job at OMFED, Applications Invited. Dairy Microbiology/Dairy Technology/ Food Technology/Dairy Chemistry applicants are eligible to apply....
Biotecnika Times Newsletter 22.09.2022 Govt OSSC Jobs, Freshers Clarivate, Pfizers Jobs
Biotecnika Times - Govt OSSC Jobs, Freshers Clarivate, Pfizers Jobs
Govt OSSC Jr. Lab Assistant Recruitment 2022 – Online Applications Invited
Biotechnology Jobs at OSSC –...
CSIR-CSMCRI BSc Plant Sciences, MSc Biotech, Biochem Project Job Openings
CSIR-CSMCRI BSc Plant Sciences, MSc Biotech, Biochem Project Job Openings
CSIR-CSMCRI BSc Plant Sciences, MSc Biotech, Biochem Project Job Openings. MSc Project Associate job openings....